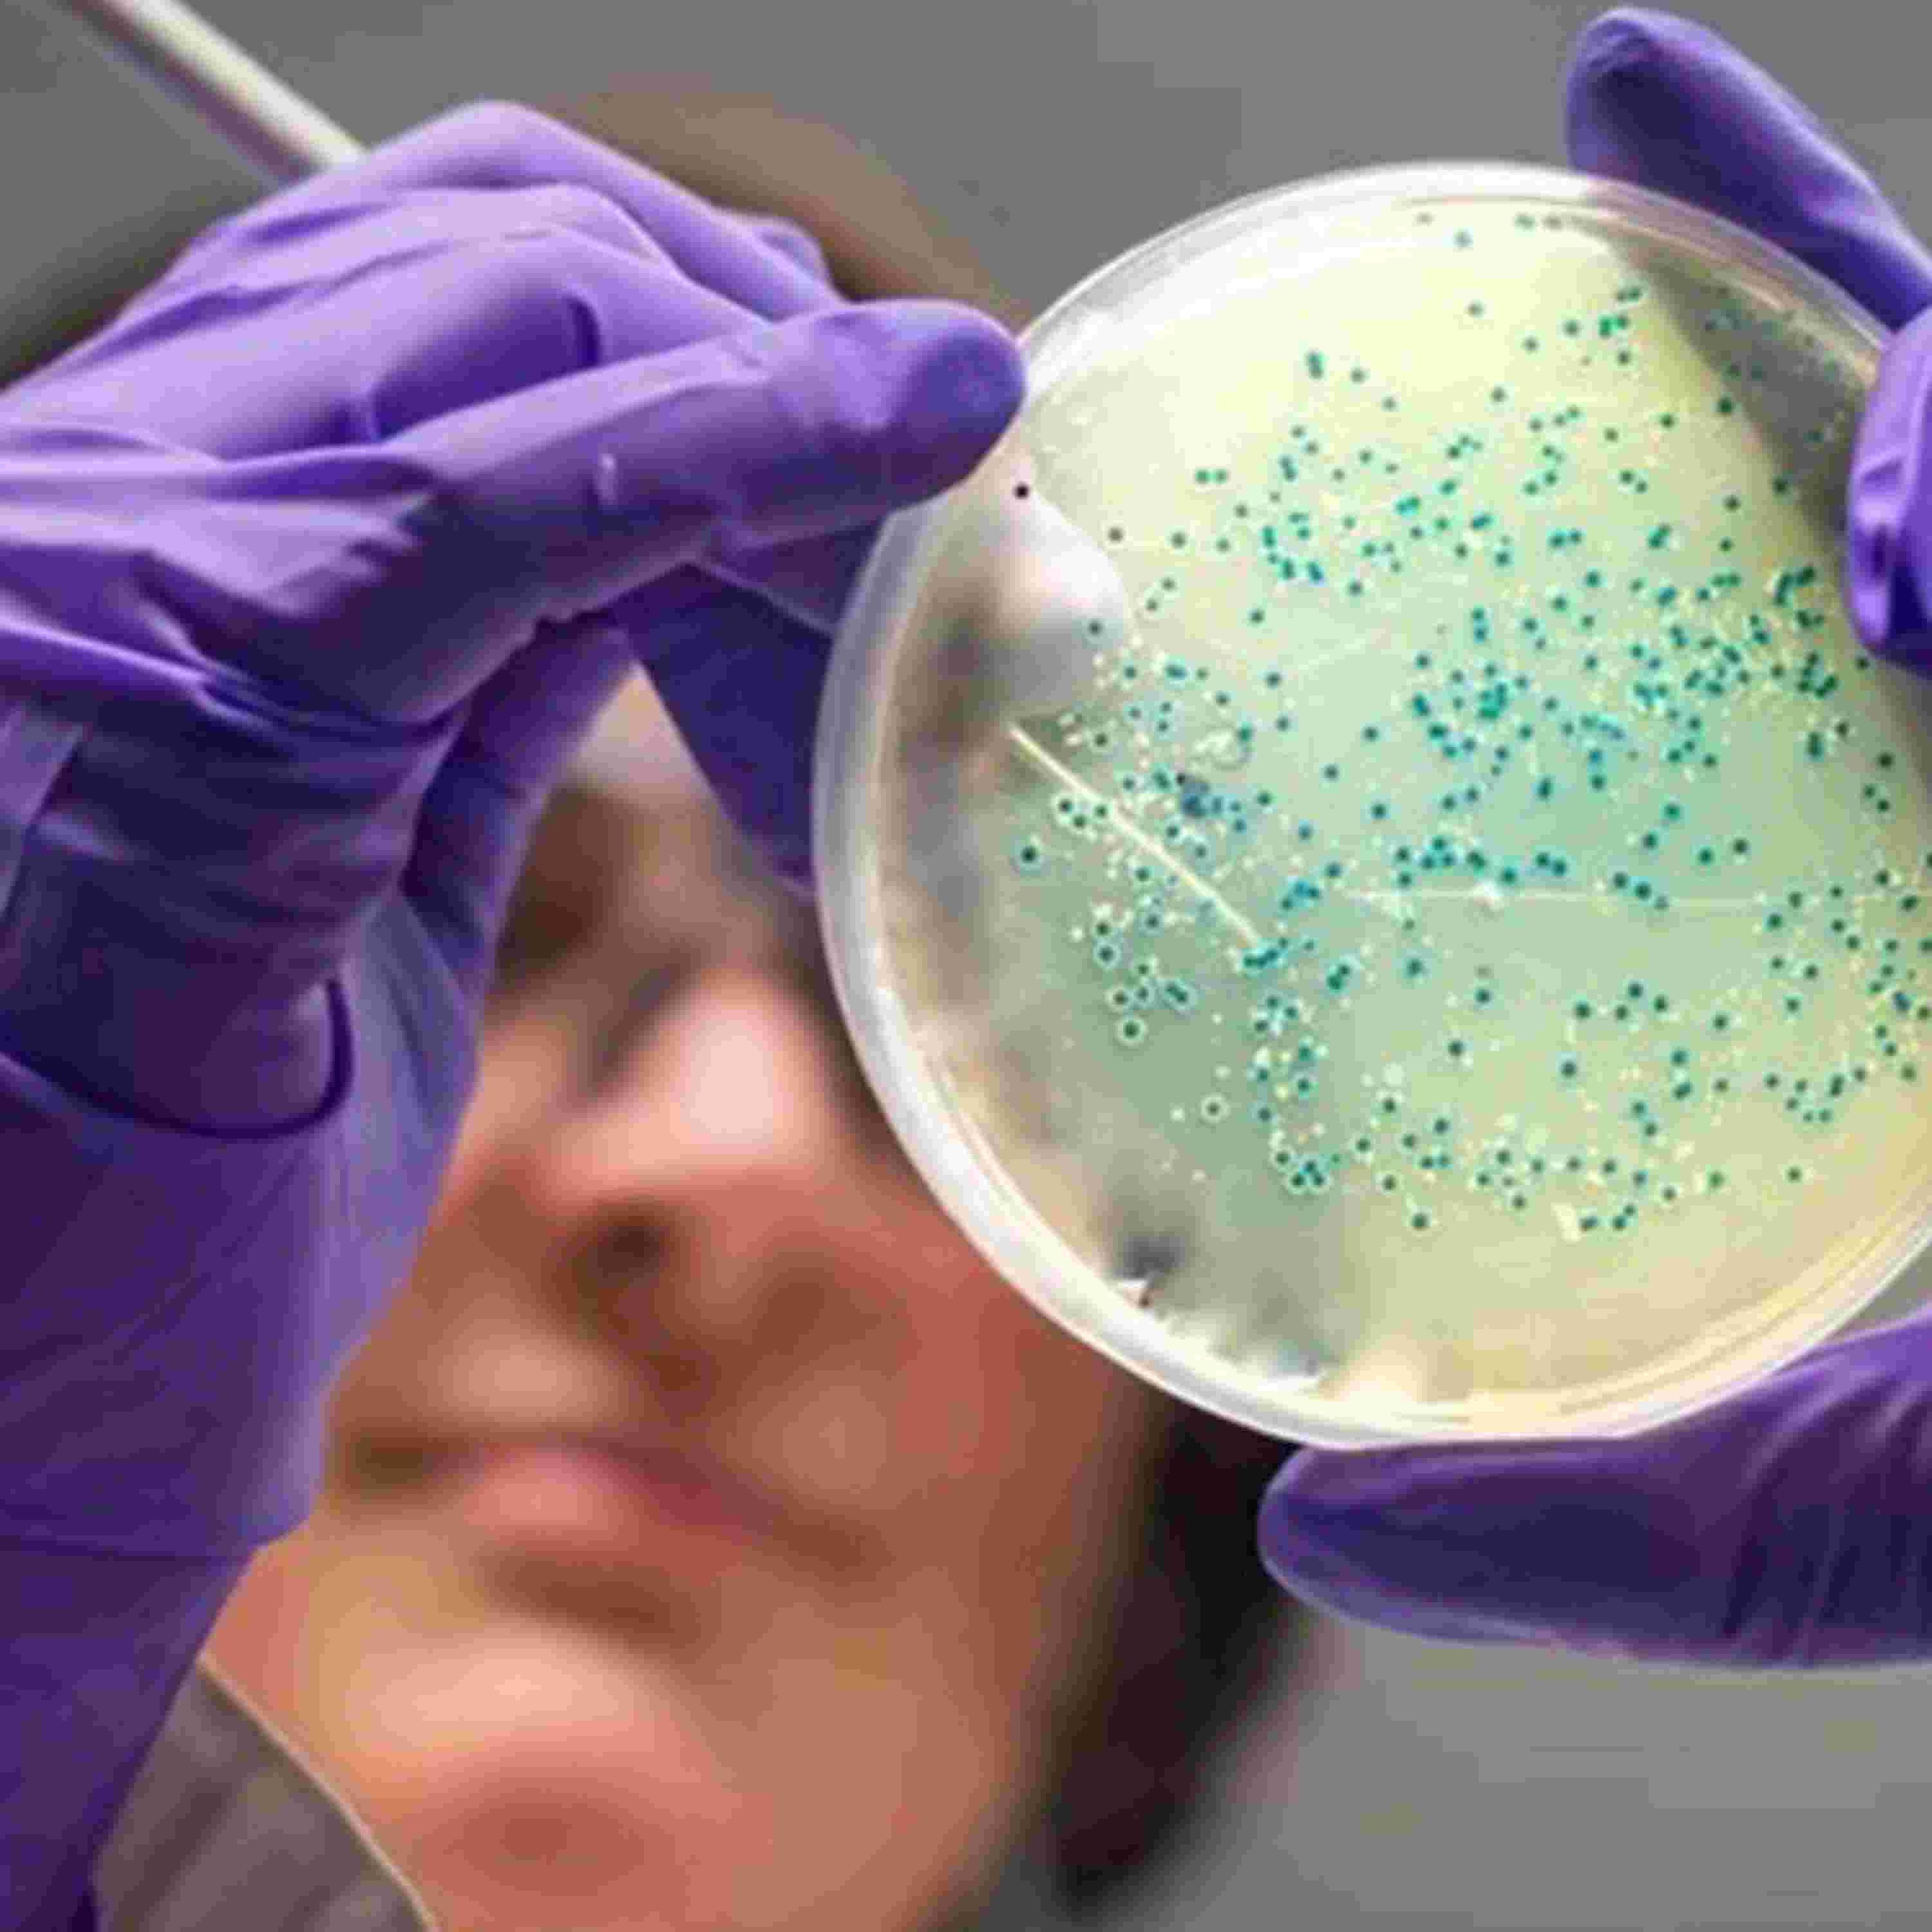
https://image.firstory-cdn.me/Image/cmdvv73j803w701w6gkn29qcs/FEu9yZH2dcKypbaoB3sFc.jpg

「春樹街聲唱盤室」是創作者蔡春樹以音樂與故事為靈感的 Podcast 節目。
每一集,就像一張留聲機唱片,被輕輕放上唱盤,隨著轉動的節奏,講述音樂背後的靈魂與城市中的聲音記憶。
節目中,春樹以自由而敏銳的觀察,串起音樂人、創作者、藝術與生活現場的片段。從街頭的原創歌聲,到巷弄裡發光的創作靈魂,每一段訪談、每一場對話,都像一次聆聽的旅程——溫柔、真實,又帶著一點實驗精神。
無論你是熱愛音樂的旅人,還是對創作故事感興趣的聽眾,「春樹街聲唱盤室」邀請你在聲音中相遇,一起體驗音樂正在發生的那一刻。
Powered by Firstory Hosting
「春樹街聲唱盤室」是創作者蔡春樹以音樂與故事為靈感的 Podcast 節目。
每一集,就像一張留聲機唱片,被輕輕放上唱盤,隨著轉動的節奏,講述音樂背後的靈魂與城市中的聲音記憶。
節目中,春樹以自由而敏銳的觀察,串起音樂人、創作者、藝術與生活現場的片段。從街頭的原創歌聲,到巷弄裡發光的創作靈魂,每一段訪談、每一場對話,都像一次聆聽的旅程——溫柔、真實,又帶著一點實驗精神。
無論你是熱愛音樂的旅人,還是對創作故事感興趣的聽眾,「春樹街聲唱盤室」邀請你在聲音中相遇,一起體驗音樂正在發生的那一刻。
Powered by Firstory Hosting
這項研究剛發表在《細胞》期刊,背後的科學家團隊由MIT醫學工程與科學研究所的詹姆斯·柯林斯教授領導。他們不是傳統意義上掃描舊有的化學資料庫,而是讓生成式人工智慧演算法逐原子設計新藥,有近3,600萬種化合物被AI分析並計算其抗微生物的潛力。研究團隊利用兩種不同的AI方法,一種是以片段拼湊分子,另一種則完全不受現有抗生素框架限制,自由創造嶄新結構。
最終,AI找到了兩個最有前景的新藥物:對抗抗藥性淋病的NG1,以及針對MRSA的DN1。這兩個分子目前看起來都有非常嶄新的殺菌機制——不是靠傳統方式,而是直接破壞細菌細胞膜,使目標細菌在動物實驗及小鼠感染模型中大量減少甚至被殺死。這代表AI不光是「加速」藥物研發,還有可能幫助人類打開抗生素發現的「第二個黃金時代」。
研究團隊的博士後研究員阿爾蒂·克里希南特別指出,這次是「徹底跳脫既有框架」來設計,探索了過去未充分涉獵的化學空間,希望找到全新機制的抗生素來解決抗微生物耐藥性危機。
免費追蹤,更新資訊不漏接: https://open.firstory.me/join/cmdvv73j803w701w6gkn29qcs
加入會員,支持節目: https://open.firstory.me/user/cmdvv73j803w701w6gkn29qcs
留言告訴我你對這一集的想法: https://open.firstory.me/user/cmdvv73j803w701w6gkn29qcs/comments